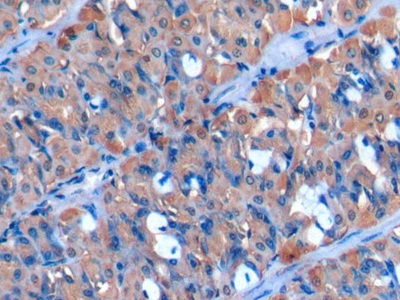
https://d1vffmuvmgkypt.cloudfront.net/image/ridacom_ltd/cloud_clone_corp/PRODUCT_SOURCE__CLOUD_CLONE__SUPPLIER__RIDACOM__ID__PAD297Hu01__1

Antigen
CP1B
Reactivity
Human
(5)
Rat
(1)
Application
Western Blotting
(3)
Enzyme-linked immunosorbent assay for Antigen Detection
(2)
Immunocytochemistry
(2)
Immunohistochemistry
(2)
Cell Culture
(1)
Immunoprecipitation
(1)
Positive Control
(1)
SDS-PAGE
(1)
Host
CHO
(1)
Rabbit
(1)
Category
Antibodies
(2)
Cell biology
(2)
ELISA Kits
(2)
Immunochemicals
(2)
Protein Biochemistry
(2)

Antigen:
Cytochrome P450 1B1
Synonyms: CP1B; GLC3A; Cytochrome P450,Family 1,Subfamily B,Polypeptide 1; Glaucoma 3,Primary Infantile
Reactivity:Human
Application:Cell Culture
Research area:Metabolic pathway
Preparation method:Escherichia coli
| 10µg | $380.00 | |
| 50µg | $950.00 | |
| 200µg | $1,900.00 |
| 1mg | $5,700.00 | |
| 5mg | $14,250.00 |

Antigen:
Cytochrome P450 1B1
Synonyms: CP1B; GLC3A; Cytochrome P450,Family 1,Subfamily B,Polypeptide 1; Glaucoma 3,Primary Infantile
Reactivity:Rat
Application:Enzyme-linked immunosorbent assay for Antigen Detection
Research area:Metabolic pathway
Test method:Double-antibody Sandwich
| 48T | $532.00 | |
| 96T | $760.00 | |
| 96T*5 | $3,420.00 |
| 96T*10 | $6,460.00 | |
| 96T*100 | $53,200.00 |

Antigen:
Cytochrome P450 1B1
Synonyms: CP1B; GLC3A; Cytochrome P450,Family 1,Subfamily B,Polypeptide 1; Glaucoma 3,Primary Infantile
Reactivity:Human
Application:Enzyme-linked immunosorbent assay for Antigen Detection
Research area:Metabolic pathway
Test method:Double-antibody Sandwich
| 48T | $490.00 | |
| 96T | $700.00 | |
| 96T*5 | $3,150.00 |
| 96T*10 | $5,950.00 | |
| 96T*100 | $49,000.00 |

Antigen:
Cytochrome P450 1B1
Synonyms: CP1B; GLC3A; Cytochrome P450,Family 1,Subfamily B,Polypeptide 1; Glaucoma 3,Primary Infantile
Reactivity:Human
Application:Positive Control; SDS-PAGE; Western Blotting
Research area:Metabolic pathway
Preparation method:Escherichia coli
| 10µg | $200.00 | |
| 50µg | $500.00 | |
| 200µg | $1,000.00 |
| 1mg | $3,000.00 | |
| 5mg | $7,500.00 |

Antigen:
Cytochrome P450 1B1
Synonyms: CP1B; GLC3A; Cytochrome P450,Family 1,Subfamily B,Polypeptide 1; Glaucoma 3,Primary Infantile
Host:CHO
Reactivity:Human
Application:Western Blotting; Immunohistochemistry; Immunocytochemistry
Research area:Metabolic pathway
| 20µl | $116.00 | |
| 100µl | $270.00 | |
| 200µl | $386.00 |
| 1ml | $965.00 | |
| 10ml | $3,860.00 |
Antigen:
Cytochrome P450 1B1
Synonyms: CP1B; GLC3A; Cytochrome P450,Family 1,Subfamily B,Polypeptide 1; Glaucoma 3,Primary Infantile
Host:Rabbit
Reactivity:Human
Application:Western Blotting; Immunohistochemistry; Immunocytochemistry; Immunoprecipitation
Clonality:Polyclonal
Research area:Metabolic pathway
| 20µl | $105.00 | |
| 100µl | $245.00 | |
| 200µl | $350.00 |
| 1ml | $875.00 | |
| 10ml | $3,500.00 |


-APD297Hu01-000001.png)


-SED297Ra-000001.png)


-SED297Hu-000001.png)




